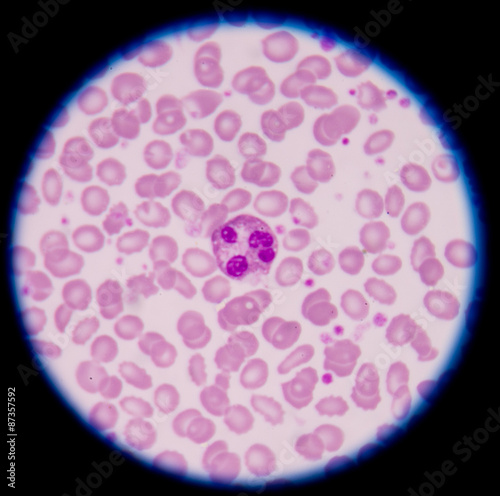
Fototapet White blood cells of a human, photomicrograph panorama as seen u
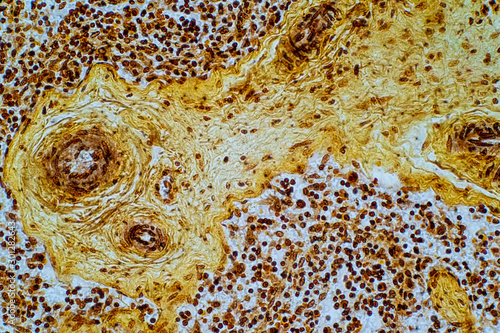
Billede på lærred Reticular cell is a type of fibroblast

-
Mærker & Merch
- Filmplakater
- Batman
- Spider-Man
- Star Wars
- Harry Potter
- MARVEL
- DISNEY
- Pokémon
- Vis alt
- Musik
- Queen
- Rolling Stones
- AC/DC
- Beatles
- Bob Marley
- Iron Maiden
- Metallica
- Vis alt
- Anime & Manga
- Attack on Titan
- Pokémon
- Demon Slayer
- Jujutsu Kaisen
- Death Note
- Dragon Ball Z
- My Hero Academia
- Vis alt
- Tegneserier
- Batman
- Spider-Man
- Superman
- Captain America
- Avengers
- MARVEL
- Wonder Woman
- Vis alt
- Spilplakater
- Assassin's Creed
- Nintendo
- Playstation
- Online spil
- Xbox
- Minecraft
- Sonic
- Vis alt
- Plakater til børn
- Harry Potter
- Minecraft
- Lilo & Stitch
- DISNEY
- Frost
- Mickey Mouse
- Princesser
- Vis alt
-
Illustrationer
- Efter motiv
- Abstrakte illustrationer
- Sort og hvid samlinger
- Rejseplakater
- Citater og tekster
- Et stykke natur
- Collagekunst
- Line Art
- Man Cave
- Mode
- Motiver til børn
- Romantik
- Sportsillustrationer
- Magazine Cover
- Women Power
- Dyr
- Daglig inspiration til dit hjem og arbejde
- Efter stil
- Bauhaus
- Øko-stil
- Retro & Vintage
- Asiatisk atmosfære
- Skandinavisk minimalisme
- Art Deco
- Boho-stil
- Parisisk elegance
- Tropisk paradis
- Pop kunst stil
- Provence stil
- Harmoni og ro
- Romantisk slotsstil
- Industriel stil
-
Billeder
- Billeder på lærred
- Billeder på lærred
- Flerdelte lærreder
- Billeder på lærred -60 %%
- Vis alt
- Billeder
- Flerdelte lærreder
- Lærredstryk med billede
- Indrammede plakater -20 %%
- Kunstreproduktioner
- Rammer og plakatophæng
- Kunstreproduktioner
- Florent Bodart
- Paul Cézanne
- Claude Monet
- Pierre-Auguste Renoir
- Sam Toft
- Leonardo da Vinci
- Alfons Mucha
- Hieronymus Bosch
- Gustav Klimt
- Wassily Kandinsky
- Leonetto Cappiello
- Vincent van Gogh
- Katsushika Hokusai
- Vis alt
-
Fotos
- Efter motiv
- Sort-hvid elegance
- Kunst omkring os
- Dyreunger
- Dyr
- Natur & landskab
- Tur rundt i verden
- Bevis for kærlighed
- Hverdagsliv
- Macro
- Eksotiske eventyr
- Minimalistisk skønhed
- Old school
- Panorama plakater
- Velsmagende verden
- Bjergenes følelse
- Set fra oven
-
Plakater
- Rammer og plakatophæng
- Rammer på lager
- Plakatophæng
- Tilbehør
- Fototapeter
- Fototapeter -60 %%
- Best Sellers
- Klistermærker
- 3D Fototapeter
- Mønstre og ornamenter
- Fototapeter med filmmotiver
- Fototapeter efter værelse
- Mærker & Merch
- Filmplakater
- Musik
- Anime & Manga
- Tegneserier
- Spilplakater
- Plakater til børn
- Sportsplakater
- Berømtheder
- Plakater
- Yndlinger - TOP
- Nyheder
- Udskriv dine fotos
- Mærker & Merch
- Sidste chance -60 %%
- Udsalg op til -80 %%
- Vægdekorationer
- Rammer og plakatophæng
- Motiver
- Abstrakt kunst
- Arkitektur
- Auto - Moto - Aero
- Berømtheder
- Dyr
- Erotiske plakater
- Fantasy & Mystery
- Fest, Fejring, Ferie
- Flag
- Fødevarer & drikkevarer
- Historie og religion
- Illustrationer
- Kort
- Kunstreproduktioner
- Lande & Byer
- Lærerige plakater - Skole
- Mode
- Motiverende plakater & Citater
- Natur & Landskab
- Rejser
- Romantik
- Sjove plakater
- Sort & hvid - Black & White
- Sportsplakater
- Til virksomheder
- Univers
- Vægdekorationer
- Metalskilte
- Plakatsæt
- Dørplakater & Dørtapet
- Møbelklistermærker
- XXL store plakater
- Panorama plakater
- Indrammede plakater -20 %%
-
Fototapeter
- Fototapeter -60 %
- Best Sellers
- Klistermærker
-
3D Fototapeter
-
Mønstre og ornamenter
-
Fototapeter med filmmotiver
- Fototapeter til teenagerens værelse
- Fototapeter til soveværelset
- Fototapeter til stuen
-
Fototapeter efter værelse
- Vis alt
-
 Motiver til børn
Motiver til børn
 Verdenskort
Verdenskort
 Natur & Landskab
Natur & Landskab
 Fototapeter til børneværelset
Fototapeter til børneværelset
-
Krus & Tallerkner
- Service
- Metaldåser og madkasser
- Flasker
- Øloplukkere
- Glasbrikker
- Glas
- Små glas
- Tallerkener & Skåle
- Tekande
- Service efter motiv
- Anime service
- Auto-moto bordservice
- Retro bordservice
- Bordservice med berømte kunstnere
- Fantasy Service
- Film & TV
- Spilleredskaber
- Tallerkner til børn
- Musik
- Tegneserie
- Sport bordservice
- Humor service
- Nyheder
-
Tøj
- Tøj
- Hættetrøjer og trøjer
- Kasketter & hatte
- Vintertøj
- Sokker
- Bukser
- Nattøj og pyjamas
- Badekåber og håndklæder
- Tasker & Rygsække
- Punge
- Smykker og skønhedstilbehør
- Paraplyer
- Gamingærmer
- Undertøj
- Nyheder
- T-shirts og toppe
- T-shirts til kvinder
- T-shirts til mænd
- T-shirts til børn
- T-shirts – Vores kollektion
- T-shirt med foto
- T-shirts -60 %%
- T-shirts - Trending
- T-shirts efter mærke
- Musik T-shirts
- Anime T-shirts
- Film- & TV T-shirts
- Gaming T-shirts
- Harry Potter
- Star Wars
- Ringenes Herre
- MARVEL
- Batman
- T-shirts efter tema
- T-shirts med berømte kunstnere
- T-shirts med sportsmotiver
- Abstrakte T-shirts
- T-shirts med asiatiske motiver
- T-shirts med Line Art
- T-shirts mad & drikke
- T-shirts med dyr
- T-shirts Auto Moto
- T-shirts med børnemotiver
- T-shirts med flag
- T-shirts med skilte og piktogrammer
- T-shirts med stjernetegn
- Sjove T-shirts
- T-shirts med citater
- Bauhaus T-shirts
- Pop Art T-shirts
- Støt Ukraine
-
T-shirts og toppe
- Hættetrøjer og trøjer
-
Kasketter & hatte
-
Vintertøj
- Sokker
- Bukser
- Nattøj og pyjamas
- Badekåber og håndklæder
-
Tasker & Rygsække
-
Punge
-
Smykker og skønhedstilbehør
- Paraplyer
- Gamingærmer
-
Tøj efter motiver
-
Tøj til:
- Undertøj
- Nyheder
- Vis alt
-
 T-shirts – Vores kollektion
T-shirts – Vores kollektion
 T-shirts til kvinder
T-shirts til kvinder
 T-shirts til mænd
T-shirts til mænd
 Musik T-shirts
Musik T-shirts
 Film- & TV T-shirts
Film- & TV T-shirts
 Gaming T-shirts
Gaming T-shirts
-
Gaver & Legetøj
- Gaver & Legetøj
- Fotogaver
- Gavekort
- Legetøj
- Kort efter eget ønske
- Perfekte gaver til
- Jul
- Gaver til mænd
- Gaver til kvinder
- Gaver til børn
- Gaver til par
- Gaver til samlere
- Gaver til elever
- Gaver til kæledyr
- Merch
- Merch til hjemmet
- Metalskilte
- Gavesæt
- Små og billige gaver
- Figurer
- Samlerobjekter replikaer
- Legetøj
- Krus & Tallerkner
- Kalendere 2027
- Kontor & skoleartikler
- Tin retro gaver
- Puslespil
- Tasker & Rygsække
- Notesbøger
- Kunstartikler
- Kommer snart
- Indrammede plakater -20 %%
- Legetøj
- Dukker
- MGA's Miniverse
- LEGO -20%%
- Bamser
- Actionfigurer og legetøj
- Modelbiler
- CarTuned
- Hot Wheels
- Spillekort
- NERF
- Brætspil
- Billedterninger
-
Til virksomheder
- Til virksomheder
- Skønhed og velvære
- Bryllupsstudie
- Gæstfrihed
- Lægens kontor
- Lærerige plakater - Skole
- Fitness-studie
- Gadernes helte
- Kontor
- Eksperter og forretningsfolk
- B2B Partners
- Skønhed og velvære
- Kosmetisk studio
- Tatovør
- Barbershop
- Wellness & Spa
- Frisørsalon
- Neglesalon
- Fitness-studie
- Træning og fitness
- Æstetik i sport
- Sportsillustrationer
- Automobilist
- Yoga
- Dans
- Fodbold
- Rammer & Indramning
- Fotogaver
Mikrofotografi - Plakater, Poster, Billeder på lærred

Kontaktinformation
FAQ
Om os
Levering og betaling
Vilkår og betingelser
Returpolitik
Privatlivspolitik
Tilbud og rabatter
Loyalitets programmet
Kundeudtalelser
Rammer & Indramning
Klistermærker
Kontakt
Samarbejde
Til kunstnere og fotografer
Til influencers og affiliate
Til bands og andre mærker
For B2B partnere
Tiskové služby pro firmy
Kort efter eget ønske
Europosters – Dekorer dit liv
Siden 1999 har Europosters været en af de mest populære sælgere af plakater, vægkunsttryk og licenserede merchandise-gaver i Tjekkiet og også i hele Europa. I vores udvalg kan du finde et stort udvalg af film-, spil- eller sportsplakater i alle størrelser samt et bredt udvalg af originale gaver til sande fans af Star Wars, Harry Potter, tegneserier eller hele Warner Bros familien. Vi ved, at krus, figurer, puslespil og tøj er den bedste gave til alle, uanset alder eller interesse. Men hvis du er fan af indretningsdesign, er du også på det rigtige sted! Vi printer vægmalerier, illustrationer, fotografier og kunstgengivelser på daglig basis og sender dem til mere end 25 lande for at holde vores kunder glade.
Kontaktinformation:
E-mail: [email protected]
Tel.: +44 20 3996 3131 (på engelsk)
Mandag – Fredag ǀ 7:00–17:00
© 1999–2025 Europosters. Alle rettigheder forbeholdes.
Vi belønner loyale kunder!
Ved at tilmelde dig accepterer du vores Fortrolighedspolitik..



































































